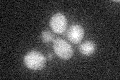
YGR103W
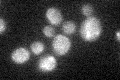
YGR103W

View description
Component of several different pre-ribosomal particles; forms a complex with Ytm1p and Erb1p that is required for maturation of the large ribosomal subunit; required for exit from G<sub>0</sub> and the initiation of cell proliferation
Localization:
Intensity:
Fold change:
Significance:
-
C’ GFP library in SD
cytosol19.23 -
N' NOP1pr-GFP in SD

mitochondria133.992 -
N' TEF2pr-mCherry in SD

missing0 -
N' NATIVEpr-GFP in SD

below threshold21.0882 -
N' TEF2pr-VC and Cyto-VN in SD

#N/A0 -
C’ GFP library in SD+DTT

cytosol17.060.88No -
C’ GFP library in SD+H2O2
cytosol17.930.93No -
C’ GFP library in Starvation Media

cytosol14.040.73No -
C’ GFP library on the background of Pup2-DaMP

N/A -
C’ GFP library on the background of CCT mutant

N/A0N/AYes
